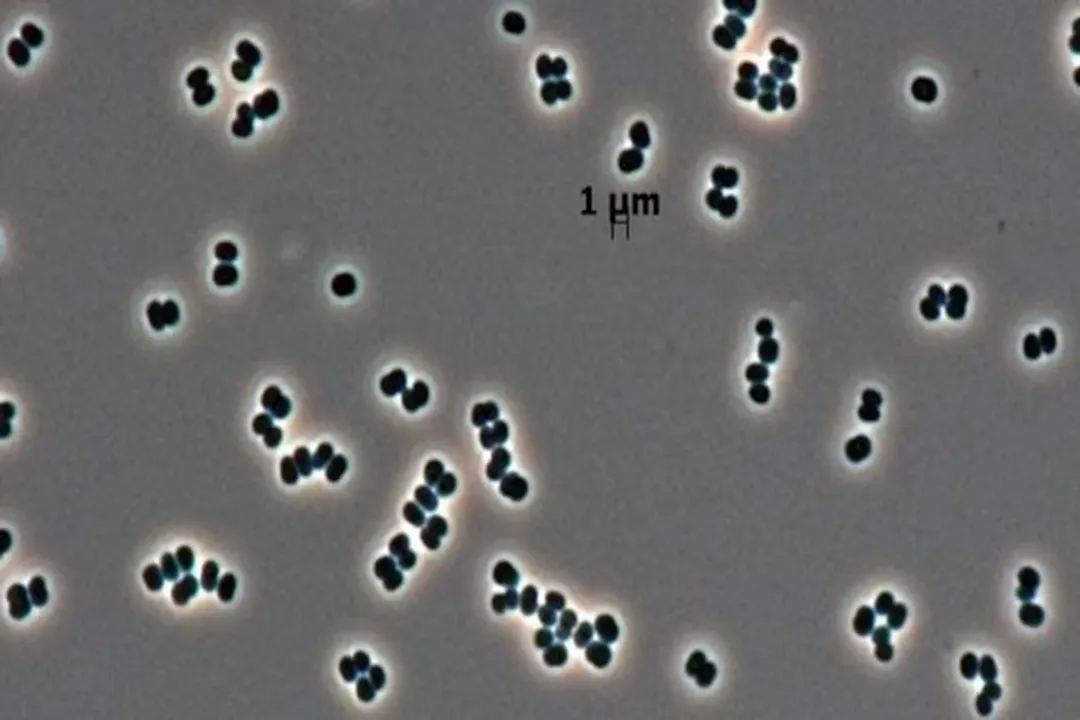
Has alien bacteria ever been found?

Has alien bacteria ever been found?
The simple, electrifying question of whether humanity has ever found a single, bona fide alien bacterium remains one of science’s most tantalizing open cases. To date, the definitive answer is no. Every time a potential microbe has been plucked from an extraterrestrial sample or discovered thriving in the ultra-sterile environment of a spacecraft, the subsequent analysis has pointed a finger right back at Earth. The search for life beyond our world is not just a matter of looking far out into the cosmos; it is intensely complicated by the life that travels with us, hitchhiking on our technology.
# Space Findings

The environment of space, with its vacuum, extreme radiation, and temperature swings, is profoundly hostile. Yet, the microscopic residents of Earth—our bacteria and fungi—have proven shockingly adaptable. This tenacity is both a marvel of biology and the central obstacle in our search for extraterrestrial organisms.
# Station Inhabitants
Microorganisms have, without question, made space their temporary home. Investigations aboard the International Space Station (ISS) have revealed a diverse microbial community existing in microgravity, including phyla like Firmicutes and Proteobacteria. Some of these microbes appear to be associated with the astronauts' own microbiomes, while others are considered opportunistic pathogens.
More dramatically, a Russian cosmonaut reported detecting living bacteria on the exterior of the ISS during spacewalks, material collected via cotton swabs that was absent when the module was launched. While this prompted immediate study by Russian researchers, the inherent hardiness of terrestrial organisms—some of which, like Deinococcus radiodurans, can survive intense radiation and replicate after years in orbit—means that concluding these were truly “from outer space” is exceedingly difficult without ruling out every possible terrestrial vector. The findings are being studied, but the shadow of contamination looms large over such claims.
# Asteroid and Meteorite Samples
When we bring pieces of other worlds back to our own, the contamination risk is immediate and severe. Consider the samples returned from asteroids or meteorites. In one notable instance involving an asteroid sample, bacteria were indeed found, but sophisticated testing confirmed they were terrestrial in origin, not alien visitors that had survived the journey. This is a recurring pattern: the extraterrestrial container often harbors Earthly stowaways that found a way in during collection, transport, or analysis on Earth.
# The Martian Ghost

Perhaps the most famous near-miss involved the Martian meteorite ALH84001, recovered in Antarctica. In 1996, a team suggested that features within this rock, blasted from Mars perhaps 16 million years ago, provided evidence for ancient, microscopic fossil life.
# Evidence and Skepticism
The case rested on three primary lines of evidence found in carbonate globules within the rock, which implied the presence of liquid water when the rock formed over 4 billion years ago:
- PAHs: Traces of polycyclic aromatic hydrocarbons, which could be microbial decay products.
- Magnetite: Microscopic grains of magnetite (iron oxide) mixed with iron sulfide, a combination often produced by bacterial metabolism.
- Morphology: Worm-like forms resembling fossilized bacteria when viewed under an electron microscope.
However, the scientific process demanded intense scrutiny. Other geochemists argued the globules could have formed at temperatures too high for Earth life. The PAHs were also found to form abiotically in interstellar clouds, weakening that line of evidence. Critically, the "fossil" shapes were often too small—down to tens of nanometers—to contain the molecular machinery, like DNA and ribosomes, known to be necessary for Earth-like life, which requires roughly a 200-nanometer sphere. While the specific shapes of the magnetite grains strongly suggested a biological origin, many scientists concluded the evidence, taken together, was consistent with life but did not require it for explanation. Though controversial, this episode drove significant renewed focus and planning for future missions designed to bring pristine samples back from Mars.
# The Contamination Conundrum
The difficulty in confirming alien life is intrinsically linked to the extreme measures taken to prevent contamination—and how even those measures sometimes select for the hardiest terrestrial life. Protecting future samples from Earth’s biology is paramount for missions like NASA's Perseverance rover, which is seeking signs of past microbial life on Mars.
# The Stealthy Stowaways
Spacecraft assembly facilities, known as clean rooms, are among the most controlled environments on Earth, employing high-efficiency filtration, biocidal fluids, UV light, and specialized procedures. Yet, this very harshness creates an evolutionary pressure cooker.
A prime example is the discovery of Tersicoccus phoenicis, a bacterium representing a new genus, found exclusively in widely separated clean rooms used for assembling spacecraft, like the Phoenix Mars Lander. This microbe is a master of evasion. Scientists determined that T. phoenicis can enter a state of deep hibernation, essentially "playing dead," which allows it to escape detection even when swab samples are placed in nutrient-rich media designed to encourage growth. It requires a specific protein, a resuscitation-promoting factor (Rpf), which is common on human skin, to reawaken and become detectable. This discovery confirmed that even after the most rigorous cleaning, a small, resilient population of microbes can survive, posing a risk not just to planetary protection protocols but also to human health in long-duration space habitats.
It strikes me that the very act of searching so intensely for known life forms in clean rooms acts as a bizarre filtering mechanism. If a microbe is common on Earth's surface, it gets overwhelmed and missed in the initial swabs; only the rare, stress-tolerant specialists that thrive in those chemically treated, low-nutrient niches—like T. phoenicis—are selected for detection. We are cataloging the organisms best equipped to survive our attempts at sterilization, rather than a true census of background life.
# Preparing for Life Elsewhere
The behavior of these terrestrial extremophiles directly informs the search for life elsewhere. For instance, the existence of magnetite crystals on Mars has spurred interest in terrestrial magnetotactic bacteria, which sequester iron as magnetite. If life evolved on Mars, it might utilize similar mineral-based biosignatures. Furthermore, understanding how Deinococcus radiodurans shields its DNA from radiation suggests potential biochemical pathways for any life that might exist on radiation-blasted surfaces like Mars.
# Thinking Beyond Earth's Blueprint
If we ever do find something truly alien, how will we know it’s not just another bizarre, undiscovered Earth microbe that evolved a novel survival trick? This is where the analysis of Martian fossil-like structures becomes a proxy for the real challenge ahead. The key question pivots on biochemistry. Would any extraterrestrial life rely on the same complex, DNA-based chemistry we observe on Earth?.
If Martian life existed billions of years ago when Mars had liquid water, it might have been a simpler, more ancient form of life that Earth outcompeted long ago—perhaps organisms much smaller than the smallest known terrestrial bacteria. This raises an interesting possibility for future analysis: Instead of searching for something identical to current Earth life, we might need to look for the building blocks of life that preceded complexity here, leaving behind chemical or structural fossils too simple to leave recognizable DNA traces.
To truly gain confidence in an extraterrestrial discovery, we must adopt a high bar for proof. An interesting analytical exercise for any future "alien" sample would be to compare its detected biosignatures against a curated database of all known, stress-adapted terrestrial hitchhikers, like T. phoenicis. If a sample contains a substance—say, a specific ratio of iron isotopes only produced by biology—and that exact signature is also present in a known, terrestrial contaminant found in the clean room, the finding is immediately suspect. The real breakthrough will be finding a signature that has no known terrestrial analogue, even among the organisms that survive our best sterilization methods.
# The Next Frontier
The current strategy is twofold: perfect planetary protection to avoid sending Earth life to contaminate other worlds, and perfect sample return to avoid tainting the evidence brought back. Missions are now being planned to retrieve Martian rocks, and when those samples arrive, they will be subjected to levels of scrutiny far exceeding anything seen before. Scientists will likely employ techniques that look not just for intact cells, but for the residual isotopic or chemical "fingerprints" of ancient life, as iron isotope analysis in magnetite might prove more definitive than mere shape.
While the vacuum of space and the harsh surfaces of other worlds have yet to yield a confirmed alien bacterium, the investigations into terrestrial life thriving in orbit or hiding in our clean rooms have only sharpened our tools and deepened our appreciation for life's sheer adaptability. The search continues, demanding rigor, skepticism, and a deeper catalog of the tenacious organisms we already know.
Related Questions
#Citations
Evidence for Microbial Life on Mars: Fossilized Bacteria? | AMNH
Bacteria 'from Outer Space' Found on Space Station, Cosmonaut Says
Rare New Microbe Found in Two Distant Clean Rooms
NASA discovered a bacteria that can 'play dead' - National Geographic

